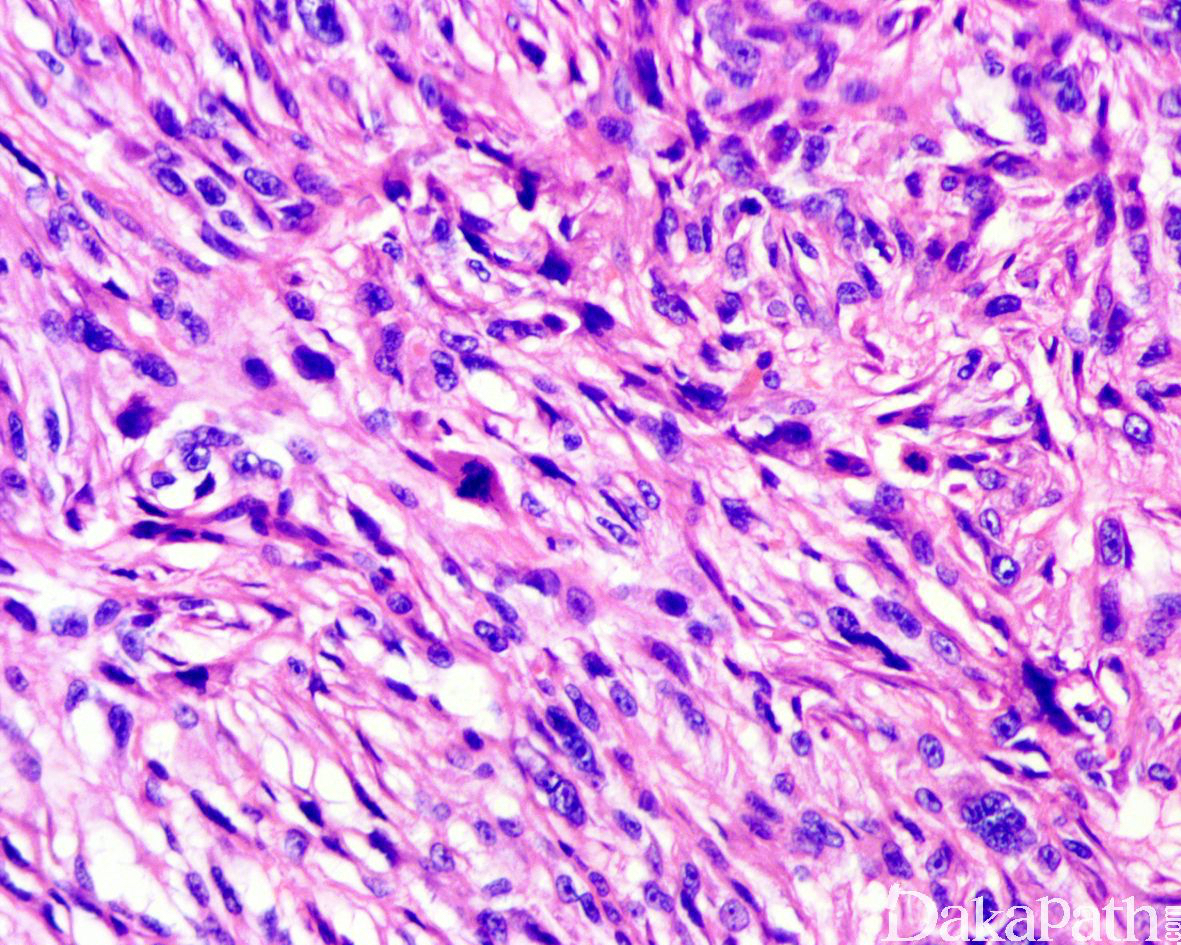

多形性皮肤肉瘤
Pleomorphic Dermal Sarcoma (PDS)
同义词(或曾用名): 皮肤多形性未分化肉瘤
概述:
发生在真皮和皮下组织的多形性未分化肉瘤,组织学特征类似于皮肤非典型纤维黄色瘤,但显示皮下浸润性生长,肿瘤性坏死、神经浸润或血管浸润等特征
发病部位: 头皮等阳光曝晒的部位最为常见
诊断要点:
多发生于老年人阳光曝晒的部位,头皮最为常见,中位发病年龄约 81 岁,男性明显多于女性;
肿瘤平均直径约 2.5cm(0.7 ~ 6cm),生长较迅速,大体上呈息肉样,结节状或斑块样生长,常见出血和溃疡形成;
镜下肿瘤的主体位于真皮或皮下,病变边界不清,两边不对称,两侧的表皮无衣领状改变,表皮常见广泛的溃疡形成,深部呈弥漫性或推挤状浸润至皮下脂肪、骨骼肌或筋膜;
肿瘤富于细胞,由非典型梭形细胞和多形性的上皮样细胞组成,比例多少不等,可见杜顿型或破骨样巨细胞,呈弥漫片状或交织束状以及席纹状排列;瘤细胞胞浆丰富,嗜酸性或浅染,核多形性明显,染色质空泡状,可见多个核仁,核分裂象活跃(平均 20 个/10HPF),常见非典型核分裂象;
半数以上可见肿瘤性坏死,25%分别可见神经浸润和血管/淋巴管浸润;
局灶可见间质黏液变性、胶原沉积、出血性囊腔形成等。

免疫组织化学染色:
肿瘤细胞弥漫表达 CD10,大多数表达 SMA,半数左右表达 CD31,少数表达 EMA, 极少见可局灶表达 P63 以及 Melan-A, 不表达 CK,CK5/6, HWCK, S100,HMB45, CD34 以及 desmin 等。
鉴别诊断:
非典型纤维黄色瘤:通常小于 2cm,镜下边界较清楚,两侧皮肤呈衣领状改变,无广泛的浸润性生长,无肿瘤性坏死、神经和血管浸润;
肉瘤样癌:仔细取材可发现至少是局灶的癌性成分,免疫组化染色表达 CK 或 P63 等;
恶性黑色素瘤:表达 HMB45 和 S100 蛋白;
高级别肉瘤样转化的隆凸性皮肤纤维肉瘤:可见典型的 DFSP 形态过渡,CD34 表达减少;
血管肉瘤:除了表达 CD31 之外尚表达 CD34. ERG 等;
浅表性 CD34 阳性的纤维母细胞肿瘤:瘤细胞可见玻璃样胞浆、核内包涵体等,弥漫表达 CD34,核分裂象低,无坏死。
治疗:
广泛切除伴或不伴有术后辅助治疗
参考文献:
Miller K , Goodlad J , Brenn T . Pleomorphic dermal sarcoma: adverse histologic features predict aggressive behavior and allow distinction from atypical fibroxanthoma[J]. American Journal of Surgical Pathology, 2012, 36(9):1317-1326.
← 腺泡状软组织肉瘤 恶性胃肠道神经外胚层肿瘤 →
